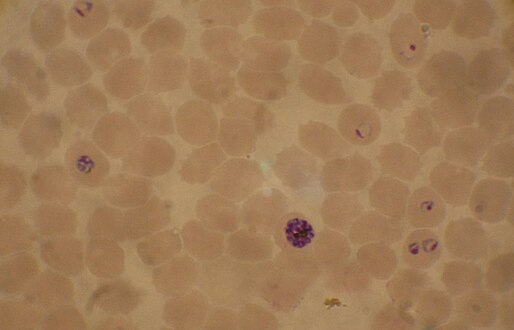
Blood smear from a P. falciparum culture (K1 strain - asexual forms) - several red blood cells have ring stages inside them. Close to the center is a schizont and on the left a trophozoite.

Plasmodium Falciparum
 From Mdwiki
From Mdwiki
| Plasmodium falciparum | |
|---|---|

| |
| Macrogametocyte (left) and microgametocyte (right) of P. falciparum | |
| Scientific classification | |
| Domain: | Eukaryota |
| Clade: | Diaphoretickes |
| Clade: | TSAR |
| Clade: | SAR |
| Clade: | Alveolata |
| Phylum: | Apicomplexa |
| Class: | Aconoidasida |
| Order: | Haemospororida |
| Family: | Plasmodiidae |
| Genus: | Plasmodium |
| Species: | P. falciparum
|
| Binomial name | |
| Plasmodium falciparum (Welch, 1897)
| |
| Synonyms[1] | |
| |
Plasmodium falciparum is a unicellular protozoan parasite of humans, and the deadliest species of Plasmodium that causes malaria in humans.[2] The parasite is transmitted through the bite of a female Anopheles mosquito and causes the disease's most dangerous form, falciparum malaria. It is responsible for around 50% of all malaria cases.[3][4] P. falciparum is therefore regarded as the deadliest parasite in humans. It is also associated with the development of blood cancer (Burkitt's lymphoma) and is classified as a Group 2A (probable) carcinogen.
The species originated from the malarial parasite Laverania found in gorillas, about 10,000 years ago.[5][6] Alphonse Laveran was the first to identify the parasite in 1880, and named it Oscillaria malariae. Ronald Ross discovered its transmission by mosquito in 1897. Giovanni Battista Grassi elucidated the complete transmission from a female anopheline mosquito to humans in 1898. In 1897, William H. Welch created the name Plasmodium falciparum, which ICZN formally adopted in 1954. P. falciparum assumes several different forms during its life cycle. The human-infective stage are sporozoites from the salivary gland of a mosquito. The sporozoites grow and multiply in the liver to become merozoites. These merozoites invade the erythrocytes (red blood cells) to form trophozoites, schizonts and gametocytes, during which the symptoms of malaria are produced. In the mosquito, the gametocytes undergo sexual reproduction to a zygote, which turns into ookinete. Ookinete forms oocytes from which sporozoites are formed.
There were 247 million cases of malaria worldwide in 2021, resulting in an estimated 619,000 deaths.[7] Nearly all malarial deaths are caused by P. falciparum, and 95% of such cases occur in Africa. Children under five years of age are most affected, accounting for 80% of the total deaths. In Sub-Saharan Africa, almost 100% of cases were due to P. falciparum, whereas in most other malarial countries, other, less virulent plasmodial species predominate.[8]
Structure[edit | edit source]
P. falciparum does not have a fixed structure but undergoes continuous change during the course of its life cycle. A sporozoite is spindle-shaped and 10–15 μm long. In the liver it grows into an ovoid schizont of 30–70 μm in diameter. Each schizont produces merozoites, each of which is roughly 1.5 μm in length and 1 μm in diameter. In the erythrocyte the merozoite form a ring-like structure, becoming a trophozoite. A trophozoites feed on the haemoglobin and forms a granular pigment called haemozoin. Unlike those of other Plasmodium species, the gametocytes of P. falciparum are elongated and crescent-shaped, by which they are sometimes identified. A mature gametocyte is 8–12 μm long and 3–6 μm wide. The ookinete is also elongated measuring about 18–24 μm. An oocyst is rounded and can grow up to 80 μm in diameter.[9] Microscopic examination of a blood film reveals only early (ring-form) trophozoites and gametocytes that are in the peripheral blood. Mature trophozoites or schizonts in peripheral blood smears, as these are usually sequestered in the tissues. On occasion, faint, comma-shaped, red dots are seen on the erythrocyte surface. These dots are Maurer's cleft and are secretory organelles that produce proteins and enzymes essential for nutrient uptake and immune evasion processes.[10]
The apical complex, which is actually a combination of organelles, is an important structure. It contains secretory organelles called rhoptries and micronemes, which are vital for mobility, adhesion, host cell invasion, and parasitophorous vacuole formation.[11] As an apicomplexan, it harbours a plastid, an apicoplast, similar to plant chloroplasts, which they probably acquired by engulfing (or being invaded by) a eukaryotic alga and retaining the algal plastid as a distinctive organelle encased within four membranes. The apicoplast is involved in the synthesis of lipids and several other compounds and provides an attractive drug target. During the asexual blood stage of infection, an essential function of the apicoplast is to produce the isoprenoid precursors isopentenyl pyrophosphate (IPP) and dimethylallyl pyrophosphate (DMAPP) via the MEP (non-mevalonate) pathway.[12]
-
Peripheral blood smear showing a ring form of Plasmodium falciparum
-
Blood smear from a P. falciparum culture (K1 strain - asexual forms) - several red blood cells have ring stages inside them. Close to the center is a schizont and on the left a trophozoite.
-
Ring forms in red blood cells (Giemsa stain)
Genome[edit | edit source]
In 1995 the Malaria Genome Project was set up to sequence the genome of P. falciparum. The genome of its mitochondrion was reported in 1995, that of the nonphotosynthetic plastid known as the apicoplast in 1996,[13] and the sequence of the first nuclear chromosome (chromosome 2) in 1998. The sequence of chromosome 3 was reported in 1999 and the entire genome was reported on 3 October 2002.[14] The roughly 24-megabase genome is extremely AT-rich (about 80%) and is organised into 14 chromosomes. Just over 5,300 genes were described. Many genes involved in antigenic variation are located in the subtelomeric regions of the chromosomes. These are divided into the var, rif, and stevor families. Within the genome, there exist 59 var, 149 rif, and 28 stevor genes, along with multiple pseudogenes and truncations. It is estimated that 551, or roughly 10%, of the predicted nuclear-encoded proteins are targeted to the apicoplast, while 4.7% of the proteome is targeted to the mitochondria.[14]
Life cycle[edit | edit source]

Humans are the intermediate hosts in which asexual reproduction occurs, and female anopheline mosquitos are the definitive hosts harbouring the sexual reproduction stage.[15]
In humans[edit | edit source]

Infection in humans begins with the bite of an infected female Anopheles mosquito. Out of about 460 species of Anopheles mosquito, more than 70 species transmit falciparum malaria.[16] Anopheles gambiae is one of the best known and most prevalent vectors, particularly in Africa.[17]
The infective stage called the sporozoite is released from the salivary glands through the proboscis of the mosquito to enter through the skin during feeding.[18] The mosquito saliva contains antihaemostatic and anti-inflammatory enzymes that disrupt blood clotting and inhibit the pain reaction. Typically, each infected bite contains 20–200 sporozoites.[11] A proportion of sporozoites invade liver cells (hepatocytes).[19] The sporozoites move in the bloodstream by gliding, which is driven by a motor made up of the proteins actin and myosin beneath their plasma membrane.[20]
Liver stage or exo-erythrocytic schizogony[edit | edit source]
Entering the hepatocytes, the parasite loses its apical complex and surface coat, and transforms into a trophozoite. Within the parasitophorous vacuole of the hepatocyte, it undergoes 13–14 rounds of mitosis and meiosis which produce a syncytial cell (coenocyte) called a schizont. This process is called schizogony. A schizont contains tens of thousands of nuclei. From the surface of the schizont, tens of thousands of haploid (1n) daughter cells called merozoites emerge. The liver stage can produce up to 90,000 merozoites,[21] which are eventually released into the bloodstream in parasite-filled vesicles called merosomes.[22]
Blood stage or erythrocytic schizogony[edit | edit source]
Merozoites use the apicomplexan invasion organelles (apical complex, pellicle and surface coat) to recognize and enter the host erythrocyte (red blood cell). The merozoites first bind to the erythrocyte in a random orientation. It then reorients such that the apical complex is in proximity to the erythrocyte membrane. The parasite forms a parasitophorous vacuole, to allow for its development inside the erythrocyte.[23] This infection cycle occurs in a highly synchronous fashion, with roughly all of the parasites throughout the blood in the same stage of development. This precise clocking mechanism has been shown to be dependent on the human host's own circadian rhythm.[24]
Within the erythrocyte, the parasite metabolism depends on the digestion of haemoglobin. The clinical symptoms of malaria such as fever, anemia, and neurological disorder are produced during the blood stage.[19]
The parasite can also alter the morphology of the erythrocyte, causing knobs on the erythrocyte membrane. Infected erythrocytes are often sequestered in various human tissues or organs, such as the heart, liver and brain. This is caused by parasite-derived cell surface proteins being present on the erythrocyte membrane, and it is these proteins that bind to receptors on human cells. Sequestration in the brain causes cerebral malaria, a very severe form of the disease, which increases the victim's likelihood of death.[25]
Trophozoite[edit | edit source]
After invading the erythrocyte, the parasite loses its specific invasion organelles (apical complex and surface coat) and de-differentiates into a round trophozoite located within a parasitophorous vacuole. The trophozoite feeds on the haemoglobin of erythrocyte, digesting its proteins and converting (by biocrystallization) the remaining heme into an insoluble and chemically inert β-hematin crystals called haemozoin.[26][27] The young trophozoite (or "ring" stage, because of its morphology on stained blood films) grows substantially before undergoing multiplication.[28]
Schizont[edit | edit source]
At the schizont stage, the parasite replicates its DNA multiple times and multiple mitotic divisions occur asynchronously.[29][30] Cell division and multiplication in the erythrocyte is called erythrocytic schizogony. Each schizont forms 16-18 merozoites.[28] The red blood cells are ruptured by the merozoites. The liberated merozoites invade fresh erythrocytes. A free merozoite is in the bloodstream for roughly 60 seconds before it enters another erythrocyte.[23]
The duration of one complete erythrocytic schizogony is approximately 48 hours. This gives rise to the characteristic clinical manifestations of falciparum malaria, such as fever and chills, corresponding to the synchronous rupture of the infected erythrocytes.[31]
Gametocyte[edit | edit source]
Some merozoites differentiate into sexual forms, male and female gametocytes. These gametocytes take roughly 7–15 days to reach full maturity, through the process called gametocytogenesis. These are then taken up by a female Anopheles mosquito during a blood meal.[32]
Incubation period[edit | edit source]
The time of appearance of the symptoms from infection (called incubation period) is shortest for P. falciparum among Plasmodium species. An average incubation period is 11 days,[31] but may range from 9 to 30 days. In isolated cases, prolonged incubation periods as long as 2, 3 or even 8 years have been recorded.[33] Pregnancy and co-infection with HIV are important conditions for delayed symptoms.[34] Parasites can be detected from blood samples by the 10th day after infection (pre-patent period).[31]
In mosquitoes[edit | edit source]
Within the mosquito midgut, the female gamete maturation process entails slight morphological changes, becoming more enlarged and spherical. The male gametocyte undergoes a rapid nuclear division within 15 minutes, producing eight flagellated microgametes by a process called exflagellation.[35] The flagellated microgamete fertilizes the female macrogamete to produce a diploid cell called a zygote. The zygote then develops into an ookinete. The ookinete is a motile cell, capable of invading other organs of the mosquito. It traverses the peritrophic membrane of the mosquito midgut and crosses the midgut epithelium. Once through the epithelium, the ookinete enters the basal lamina, and settles to an immotile oocyst. For several days, the oocyst undergoes 10 to 11 rounds of cell division to create a syncytial cell (sporoblast) containing thousands of nuclei. Meiosis takes place inside the sporoblast to produce over 3,000 haploid daughter cells called sporozoites on the surface of the mother cell.[36] Immature sporozoites break through the oocyst wall into the haemolymph. They migrate to the mosquito salivary glands where they undergo further development and become infective to humans.[19]
Interaction with human immune system[edit | edit source]
Immune response[edit | edit source]
A single anopheline mosquito can transmit hundreds of P. falciparum sporozoites in a single bite under experimental conditions. But in nature the number is generally less than 80.[37] The sporozoites do not enter the blood stream directly and remain in the skin tissue for 2 to 3 hours. About 15–20% sporozoites enter the lymphatic system where they activate dendritic cells, which send them for destruction by T lymphocytes (CD8+ T cells). At 48 hours after infection, Plasmodium-specific CD8+ T cells can be detected in the lymph nodes connected to the skin cells.[38] Most of the sporozoites remaining in the skin tissue are subsequently killed by the innate immune system. The sporozoite glycoprotein specifically activates mast cells. The mast cells then produce signaling molecules such as TNFα and MIP-2, which activate cell eaters (professional phagocytes) such as neutrophils and macrophages.[39]
Only a small number (0.5-5%) of sporozoites enter the blood stream into the liver. In the liver, the activated CD8+ T cells from the lymph bind the sporozoites through the circumsporozoite protein (CSP).[38] Antigen presentation by dendritic cells in the skin tissue to T cells is also a crucial process. From this stage onward the parasites produce different proteins that help in suppressing communication of the immune cells.[40] Even at the height of the infection when red blood cells (RBCs) are ruptured, the immune signals are not strong enough to activate macrophages or natural killer cells.[41]
Immune system evasion[edit | edit source]
Although P. falciparum is easily recognized by human immune system while in the bloodstream, it evades immunity by producing over 2,000 cell membrane antigens.[42] The initial infective stage sporozoites produce circumsporozoite protein (CSP), which binds to hepatocytes.[43] Binding to and entry into the hepatocytes is aided by another protein, thrombospondin-related anonymous protein (TRAP).[44] TRAP and other secretory proteins (including sporozoite microneme protein essential for cell traversal 1, SPECT1 and SPECT2) from microneme allow the sporozoite to move through the blood, avoiding immune cells and penetrating hepatocytes.[45]
During erythrocyte invasion, merozoites release merozoite cap protein-1 (MCP1), apical membrane antigen 1 (AMA1), erythrocyte-binding antigens (EBA), myosin A tail domain interacting protein (MTIP), and merozoite surface proteins (MSPs).[42] Of these MSPs, MSP1 and MSP2 are primarily responsible for avoiding immune cells.[46] The virulence of P. falciparum is mediated by erythrocyte membrane proteins, which are produced by the schizonts and trophozoites inside the erythrocytes and are displayed on the erythrocyte membrane. PfEMP1 is the most important, capable of acting as both an antigen and an adhesion molecule.[47]
Distribution and epidemiology[edit | edit source]
_species_by_country_of_origin_for_imported_cases_to_non-endemic_countries.png)
P. falciparum is endemic in 84 countries,[7] and is found in all continents except Europe. Historically, it was present in most European countries, but improved health conditions led to the disappearance in the early 20th century.[49] The only European country where it used to be historically prevalent, and from where we got the name malaria, Italy had been declared malaria-eradicated country. In 1947, the Italian government launched the National Malaria Eradication Program, and following, an anti-mosquito campaign was implemented using DDT.[50] The WHO declared Italy free of malaria in 1970.[51]
There were 247 million cases of malaria worldwide in 2021, resulting in an estimated 619,000 deaths.[7] The infection is most prevalent in Africa, where 94% of malaria deaths occur. Children under five years of age are most affected, and 67% of malaria deaths occurred in this age group. 80% of the infection is found in Sub-Saharan Africa, 7% in the South-East Asia, and 2% in the Eastern Mediterranean. Nigeria has the highest incidence, with 27% of the total global cases. Outside Africa, India has the highest incidence, with 4.5% of the global burden. Europe is regarded as a malaria-free region. Historically, the parasite and its disease had been most well known in Europe. But medical programmes since the early 20th century, such as insecticide spraying, drug therapy and environmental engineering, resulted in complete eradication in the 1970s.[52] It is estimated that approximately 2.4 billion people are at constant risk of infection.[53]
Infection[edit | edit source]
The clinical symptoms of falciparum malaria are produced by the rupture and destruction of erythrocytes by the merozoites. High fever, called paroxysm, is the most basic indication. The fever has a characteristic cycle of hot stage, cold stage and sweating stages.[54] Since each erythrocytic schizogony takes a cycle of 48 hours, i.e., two days, the febrile symptom appears every third day. This is the reason the infection is classically named tertian malignant fever (tertian, a derivative of Latin word that means "third").[55][56] The most common symptoms are fever (>92% of cases), chills (79%), headaches (70%), and sweating (64%). Dizziness, malaise, muscle pain, abdominal pain, nausea, vomiting, mild diarrhea, and dry cough are also generally associated. High heartrate, jaundice, pallor, orthostatic hypotension, enlarged liver, and enlarged spleen are also diagnosed.[31]
The insoluble β-hematin crystals, haemozoin, produced from digestion of haemoglobin of the RBCs is the main agent that affect body organs. Acting as a blood toxin, haemozoin-containing RBCs cannot be attacked by phagocytes during immune response to malaria.[57] The phagocytes can ingest free haemozoins liberated after the rupture of RBCs by which they are induced to initiate chains of inflammatory reaction that results in increased fever.[58][59] It is the haemozoin that is deposited in body organs such as the spleen and liver, as well as in kidneys and lungs, to cause their enlargement and discolouration.[60][61] Because of this, haemozoin is also known as malarial pigment.[62][63]
Unlike other malarias, which show regular periodicity of fever, falciparum, though exhibiting a 48-hour cycle, usually presents as irregular bouts of fever. This difference is due the ability of P. falciparum merozoites to invade a large number of RBCs sequentially without coordinated intervals, which is not seen in other malarial parasites.[54] P. falciparum is therefore responsible for almost all severe human illnesses and deaths due to malaria, in a condition called pernicious or complicated or severe malaria. Complicated malaria occurs more commonly in children under age 5,[31] and sometimes in pregnant women (a condition specifically called pregnancy-associated malaria).[64] Women become susceptible to severe malaria during their first pregnancy. Susceptibility to severe malaria is reduced in subsequent pregnancies due to increased antibody levels against variant surface antigens that appear on infected erythrocytes.[65] But increased immunity in the mother increases susceptibility to malaria in newborn babies.[64]
P. falciparum works via sequestration, a process by which group of infected RBCs are clustered, which is not exhibited by any other species of malarial parasites.[66] The mature schizonts change the surface properties of infected erythrocytes, causing them to stick to blood vessel walls (cytoadherence). This leads to obstruction of the microcirculation and results in dysfunction of multiple organs, such as the brain in cerebral malaria.[67]
Cerebral malaria is the most dangerous condition of any malarial infection and the most severe form of neurological disorders. According to the WHO definition, the clinical symptom is indicated by coma and diagnosis by high level of merozoites in the peripheral blood samples.[68][69] It is the deadliest form of malaria, and to it are attributed to 0.2 million to over a million annual deaths throughout the ages. Most deaths are of children of below 5 years of age.[70][71] It occurs when the merozoites invade the brain and causes brain damage of varying degrees. Death is caused by oxygen deprivation (hypoxia) due to inflammatory cytokine production and vascular leakage induced by the merozoites.[72] Among the surviving individuals, persistent medical conditions such as neurological impairment, intellectual disability, and behavioural problems exist. Among them, epilepsy is the most common condition, and cerebral malaria is the leading cause of acquired epilepsy among African children.[73]
The reappearance of falciparum symptom, a phenomenon called recrudescence, is often seen in survivors.[74] Recrudescence can occur even after successful antimalarial medication.[75][76] It may take a few months or even several years. In some individuals, it takes as along as three years.[77] In isolated cases, the duration can reach or exceed 10 years.[78][79] It is also a common incident among pregnant women.[80][81]
Genetic resistance[edit | edit source]
The high mortality and morbidity caused by P. falciparum has placed great selective pressure on the human genome. Several genetic factors provide some resistance to Plasmodium infection, including sickle cell trait, thalassaemia traits, glucose-6-phosphate dehydrogenase deficiency, and the absence of Duffy antigens on red blood cells.[82][83] E. A. Beet, a doctor working in Southern Rhodesia (now Zimbabwe) had observed in 1948 that sickle-cell disease was related to a lower rate of malaria infections.[84] This suggestion was reiterated by J. B. S. Haldane in 1948, who suggested that thalassaemia might provide similar protection.[85] This hypothesis has since been confirmed and extended to hemoglobin E[86] and hemoglobin C.[87]
Prevention[edit | edit source]
RTS,S is the only candidate as malaria vaccine to have gone through clinical trials.[88] Analysis of the results of the phase III trial (conducted between 2011 and 2016) revealed a rather low efficacy (20-39% depending on age, with up to 50% in 5–17-month aged babies), indicating that the vaccine will not lead to full protection and eradication.[89]
On October 6, 2021, the World Health Organization recommended malaria vaccination for children at risk.[90]
Treatment[edit | edit source]
Uncomplicated malaria[edit | edit source]
According to WHO guidelines 2010,[91] artemisinin-based combination therapies (ACTs) are the recommended first-line antimalarial treatments for uncomplicated malaria caused by P. falciparum. WHO recommends combinations such as artemether/lumefantrine, artesunate/amodiaquine, artesunate/mefloquine, artesunate/sulfadoxine/pyrimethamine, and dihydroartemisinin/piperaquine.[91]
The choice of ACT is based on the level of resistance to the constituents in the combination. Artemisinin and its derivatives are not appropriate for monotherapy. As second-line antimalarial treatment, when initial treatment does not work, an alternative ACT known to be effective in the region is recommended, such as artesunate plus tetracycline or doxycycline or clindamycin, and quinine plus tetracycline or doxycycline or clindamycin. Any of these combinations is to be given for 7 days. For pregnant women, the recommended first-line treatment during the first trimester is quinine plus clindamycin for 7 days.[91] Artesunate plus clindamycin for 7 days is indicated if this treatment fails. For travellers returning to nonendemic countries, atovaquone/proguanil, artemether/lumefantrineany and quinine plus doxycycline or clindamycin are recommended.[91]
Severe malaria[edit | edit source]
For adults, intravenous (IV) or intramuscular (IM) artesunate is recommended.[91] Quinine is an acceptable alternative if parenteral artesunate is not available.[91]
For children, especially in the malaria-endemic areas of Africa, artesunate IV or IM, quinine (IV infusion or divided IM injection), and artemether IM are recommended.[91]
Parenteral antimalarials should be administered for a minimum of 24 hours, irrespective of the patient's ability to tolerate oral medication earlier.[91] Thereafter, complete treatment is recommended including complete course of ACT or quinine plus clindamycin or doxycycline.[91]
History[edit | edit source]
In 1640, Huan del Vego first employed the tincture of the cinchona bark for treating malaria; the native Indians of Peru and Ecuador had been using it even earlier for treating fevers. Thompson (1650) introduced this "Jesuits' bark" to England. Its first recorded use there was by John Metford of Northampton in 1656. Morton (1696) presented the first detailed description of the clinical picture of malaria and of its treatment with cinchona. Gize (1816) studied the extraction of crystalline quinine from the cinchona bark and Pelletier and Caventou (1820) in France extracted pure quinine alkaloids, which they named quinine and cinchonine.[92][93] The total synthesis of quinine was achieved by American chemists R.B. Woodward and W.E. Doering in 1944. Woodward received the Nobel Prize in Chemistry in 1965.[94]
Attempts to make synthetic antimalarials began in 1891. Atabrine, developed in 1933, was used widely throughout the Pacific in World War II, but was unpopular because of its adverse effects.[95] In the late 1930s, the Germans developed chloroquine, which went into use in the North African campaigns. Creating a secret military project called Project 523, Mao Zedong encouraged Chinese scientists to find new antimalarials after seeing the casualties in the Vietnam War. Tu Youyou discovered artemisinin in the 1970s from sweet wormwood (Artemisia annua). This drug became known to Western scientists in the late 1980s and early 1990s and is now a standard treatment. Tu won the Nobel Prize in Physiology or Medicine in 2015.[96]
Carcinogen[edit | edit source]
The International Agency for Research on Cancer (IARC) has classified malaria due to P. falciparum as Group 2A carcinogen, meaning that the parasite is probably a cancer-causing agent in humans.[97] Its association with a blood cell (lymphocyte) cancer called Burkitt's lymphoma is established. Burkitt's lymphoma was discovered by Denis Burkitt in 1958 from African children, and he later speculated that the cancer was likely due to certain infectious diseases. In 1964, a virus, later called Epstein–Barr virus (EBV) after the discoverers, was identified from the cancer cells. The virus was subsequently proved to be the direct cancer agent, and is now classified as Group 1 carcinogen.[98]
In 1989, it was realised that EBV requires other infections such as with malaria to cause lymphocyte transformation. It was reported that the incidence of Burkitt's lymphoma decreased with effective treatment of malaria over several years.[99] The actual role played by P. falciparum remained unclear for the next two-and-half decades. EBV had been known to induce lymphocytes to become cancerous using its viral proteins (antigens such as EBNA-1, EBNA-2, LMP-1, and LMP2A).[100][101] From 2014, it became clear that P. falciparum contributes to the development of the lymphoma. P. falciparum-infected erythrocytes directly bind to B lymphocytes through the CIDR1α domain of PfEMP1. This binding activates toll-like receptors (TLR7 and TLR10) causing continuous activation of lymphocytes to undergo proliferation and differentiation into plasma cells, thereby increasing the secretion of IgM and cytokines.[102] This in turn activates an enzyme called activation-induced cytidine deaminase (AID), which tends to cause mutation in the DNA (by double-strand break) of an EBV-infected lymphocytes. The damaged DNA undergoes uncontrolled replication, thus making the cell cancerous.[103]
History[edit | edit source]

Falciparum malaria was familiar to the ancient Greeks, who gave the general name πυρετός (pyretós) "fever".[104] Hippocrates (c. 460–370 BCE) gave several descriptions on tertian fever and quartan fever.[105] It was prevalent throughout the ancient Egyptian and Roman civilizations.[106] It was the Romans who named the disease "malaria"—mala for bad, and aria for air, as they believed that the disease was spread by contaminated air, or miasma.[105][107]
Discovery[edit | edit source]
A German physician, Johann Friedrich Meckel, must have been the first to see P. falciparum but without knowing what it was. In 1847, he reported the presence of black pigment granules from the blood and spleen of a patient who died of malaria. The French Army physician Charles Louis Alphonse Laveran, while working at Bône Hospital (now Annaba in Algeria), correctly identified the parasite as a causative pathogen of malaria in 1880. He presented his discovery before the French Academy of Medicine in Paris, and published it in The Lancet in 1881. He gave it the scientific name Oscillaria malariae.[107] However, his discovery was received with skepticism, mainly because by that time, leading physicians such as Theodor Albrecht Edwin Klebs and Corrado Tommasi-Crudeli claimed that they had discovered a bacterium (which they called Bacillus malariae) as the pathogen of malaria. Laveran's discovery was only widely accepted after five years when Camillo Golgi confirmed the parasite using better microscopes and staining techniques. Laveran was awarded the Nobel Prize in Physiology or Medicine in 1907 for his work. In 1900, the Italian zoologist Giovanni Battista Grassi categorized Plasmodium species based on the timing of fever in the patient; malignant tertian malaria was caused by Laverania malariae (now P. falciparum), benign tertian malaria by Haemamoeba vivax (now P. vivax), and quartan malaria by Haemamoeba malariae (now P. malariae).[108]
The British physician Patrick Manson formulated the mosquito-malaria theory in 1894; until that time, malarial parasites were believed to be spread in air as miasma, a Greek word for pollution.[107] His colleague Ronald Ross of the Indian Medical Service validated the theory while working in India. Ross discovered in 1897 that malarial parasites lived in certain mosquitoes. The next year, he demonstrated that a malarial parasite of birds could be transmitted by mosquitoes from one bird to another. Around the same time, Grassi demonstrated that P. falciparum was transmitted in humans only by female anopheline mosquito (in his case Anopheles claviger).[109] Ross, Manson and Grassi were nominated for the Nobel Prize in Physiology or Medicine in 1902. Under controversial circumstances, only Ross was selected for the award.[110]
There was a long debate on the taxonomy. It was only in 1954 the International Commission on Zoological Nomenclature officially approved the binominal Plasmodium falciparum.[111] The valid genus Plasmodium was created by two Italian physicians Ettore Marchiafava and Angelo Celli in 1885. The Greek word plasma means "mould" or "form"; oeidēs meaning "to see" or "to know." The species name was introduced by an American physician William Henry Welch in 1897.[112] It is derived from the Latin falx, meaning "sickle" and parum meaning "like or equal to another".[111]
Evolution[edit | edit source]
P. falciparum is now generally accepted to have evolved from Laverania (a subgenus of Plasmodium found in apes) species present in gorilla in Western Africa.[113][114] Genetic diversity indicates that the human protozoan emerged around 10,000 years ago.[5][6] The closest relative of P. falciparum is P. praefalciparum, a parasite of gorillas, as supported by mitochondrial, apicoplastic and nuclear DNA sequences.[115][116][117] These two species are closely related to the chimpanzee parasite P. reichenowi, which was previously thought to be the closest relative of P. falciparum. P. falciparum was also once thought to originate from a parasite of birds.[118]
Levels of genetic polymorphism are extremely low within the P. falciparum genome compared to that of closely related, ape infecting species of Plasmodium (including P. praefalciparum).[119][115] This suggests that the origin of P. falciparum in humans is recent, as a single P. praefalciparum strain became capable of infecting humans.[115] The genetic information of P. falciparum has signaled a recent expansion that coincides with the agricultural revolution. It is likely that the development of extensive agriculture increased mosquito population densities by giving rise to more breeding sites, which may have triggered the evolution and expansion of P. falciparum.[120]
See also[edit | edit source]
References[edit | edit source]
- ↑ Coatney GR, Collins WE, Warren M, Contacos PG (1971). "22 Plasmodium falciparum (Welch, 1897)". The primate malarias. Division of Parasitic Disease, CDC. p. 263. Archived from the original on 2019-08-26. Retrieved 2023-05-19.
- ↑ Rich, S. M.; Leendertz, F. H.; Xu, G.; Lebreton, M.; Djoko, C. F.; Aminake, M. N.; Takang, E. E.; Diffo, J. L. D.; Pike, B. L.; Rosenthal, B. M.; Formenty, P.; Boesch, C.; Ayala, F. J.; Wolfe, N. D. (2009). "The origin of malignant malaria". Proceedings of the National Academy of Sciences. 106 (35): 14902–14907. Bibcode:2009PNAS..10614902R. doi:10.1073/pnas.0907740106. PMC 2720412. PMID 19666593.
- ↑ Perkins, D. J.; Were, T.; Davenport, G. C.; Kempaiah, P.; Hittner, J. B.; Ong'Echa, J. M. (2011). "Severe malarial anemia: Innate immunity and pathogenesis". International Journal of Biological Sciences. 7 (9): 1427–1442. doi:10.7150/ijbs.7.1427. PMC 3221949. PMID 22110393.
- ↑ Perlmann, P; Troye-Blomberg, M (2000). "Malaria blood-stage infection and its control by the immune system". Folia Biologica. 46 (6): 210–8. PMID 11140853.
- ↑ 5.0 5.1 Loy, Dorothy E.; Liu, Weimin; Li, Yingying; Learn, Gerald H.; Plenderleith, Lindsey J.; Sundararaman, Sesh A.; Sharp, Paul M.; Hahn, Beatrice H. (2017). "Out of Africa: origins and evolution of the human malaria parasites Plasmodium falciparum and Plasmodium vivax". International Journal for Parasitology. 47 (2–3): 87–97. doi:10.1016/j.ijpara.2016.05.008. PMC 5205579. PMID 27381764.
- ↑ 6.0 6.1 Sharp, Paul M.; Plenderleith, Lindsey J.; Hahn, Beatrice H. (2020). "Ape origins of human malaria". Annual Review of Microbiology. 74: 39–63. doi:10.1146/annurev-micro-020518-115628. PMC 7643433. PMID 32905751. Archived from the original on 2023-04-08. Retrieved 2023-05-19.
- ↑ 7.0 7.1 7.2 WHO (2022). World Malaria Report 2022. Switzerland: World Health Organization. ISBN 978-92-4-006489-8. Archived from the original on 2023-05-07. Retrieved 2023-05-19.
- ↑ WHO (2021). World Malaria Report 2021. Switzerland: World Health Organization. ISBN 978-92-4-004049-6. Archived from the original on 2023-05-06. Retrieved 2023-05-19.
- ↑ Lucius, R.; Roberts, C.W. (2017). "Biology of Parasitic Protozoa". In Lucius, R.; Loos-Frank, B.; Lane, R.P.; Poulin, R.; Roberts, C.W.; Grencis, R.K. (eds.). The Biology of Parasites. John Wiley & Sons. pp. 190–198. ISBN 978-3-527-32848-2. Archived from the original on 2023-07-01. Retrieved 2023-05-19.
- ↑ Lanzer, Michael; Wickert, Hannes; Krohne, Georg; Vincensini, Laetitia; Braun Breton, Catherine (2006). "Maurer's clefts: A novel multi-functional organelle in the cytoplasm of Plasmodium falciparum-infected erythrocytes". International Journal for Parasitology. 36 (1): 23–36. doi:10.1016/j.ijpara.2005.10.001. PMID 16337634.
- ↑ 11.0 11.1 Garcia, J. E.; Puentes, A.; Patarroyo, M. E. (2006). "Developmental Biology of Sporozoite-Host Interactions in Plasmodium falciparum Malaria: Implications for Vaccine Design". Clinical Microbiology Reviews. 19 (4): 686–707. doi:10.1128/CMR.00063-05. PMC 1592691. PMID 17041140.
- ↑ Yeh, Ellen; DeRisi, Joseph L. (2011-08-30). "Chemical Rescue of Malaria Parasites Lacking an Apicoplast Defines Organelle Function in Blood-Stage Plasmodium falciparum". PLOS Biol. 9 (8): e1001138. doi:10.1371/journal.pbio.1001138. ISSN 1545-7885. PMC 3166167. PMID 21912516.
- ↑ Wilson RJ; Denny PW; Preiser PR; et al. (August 1996). "Complete gene map of the plastid-like DNA of the malaria parasite Plasmodium falciparum". Journal of Molecular Biology. 261 (2): 155–72. doi:10.1006/jmbi.1996.0449. PMID 8757284.
- ↑ 14.0 14.1 Gardner MJ; Hall N; Fung E; et al. (October 2002). "Genome sequence of the human malaria parasite Plasmodium falciparum". Nature. 419 (6906): 498–511. Bibcode:2002Natur.419..498G. doi:10.1038/nature01097. PMC 3836256. PMID 12368864.
- ↑ Lee, Wenn-Chyau; Russell, Bruce; Rénia, Laurent (2019). "Sticking for a Cause: The Falciparum Malaria Parasites Cytoadherence Paradigm". Frontiers in Immunology. 10: 1444. doi:10.3389/fimmu.2019.01444. PMC 6610498. PMID 31316507.
- ↑ Molina-Cruz, Alvaro; Zilversmit, Martine M.; Neafsey, Daniel E.; Hartl, Daniel L.; Barillas-Mury, Carolina (2016). "Mosquito Vectors and the Globalization of Plasmodium falciparum Malaria". Annual Review of Genetics. 50 (1): 447–465. doi:10.1146/annurev-genet-120215-035211. PMID 27732796. Archived from the original on 2023-04-07. Retrieved 2023-05-19.
- ↑ Sinka, Marianne E; Bangs, Michael J; Manguin, Sylvie; Coetzee, Maureen; Mbogo, Charles M; Hemingway, Janet; Patil, Anand P; Temperley, Will H; Gething, Peter W; Kabaria, Caroline W; Okara, Robi M; Van Boeckel, Thomas; Godfray, H Charles J; Harbach, Ralph E; Hay, Simon I (2010). "The dominant Anopheles vectors of human malaria in Africa, Europe and the Middle East: occurrence data, distribution maps and bionomic pr?cis". Parasites & Vectors. 3 (1): 117. doi:10.1186/1756-3305-3-117. PMC 3016360. PMID 21129198.
- ↑ Ménard, R; Tavares, J; Cockburn, I; Markus, M; Zavala, F; Amino, R (2013). "Looking under the skin: the first steps in malarial infection and immunity". Nature Reviews Microbiology. 11 (10): 701–712. doi:10.1038/nrmicro3111. PMID 24037451. S2CID 21437365.
- ↑ 19.0 19.1 19.2 Gerald, N.; Mahajan, B.; Kumar, S. (2011). "Mitosis in the Human Malaria Parasite Plasmodium falciparum". Eukaryotic Cell. 10 (4): 474–482. doi:10.1128/EC.00314-10. PMC 3127633. PMID 21317311.
- ↑ Kappe, SH; Buscaglia, CA; Bergman, LW; Coppens, I; Nussenzweig, V (2004). "Apicomplexan gliding motility and host cell invasion: overhauling the motor model". Trends in Parasitology. 20 (1): 13–16. CiteSeerX 10.1.1.458.5746. doi:10.1016/j.pt.2003.10.011. PMID 14700584.
- ↑ Vaughan, Ashley M.; Kappe, Stefan H.I. (2017). "Malaria Parasite Liver Infection and Exoerythrocytic Biology". Cold Spring Harbor Perspectives in Medicine. 7 (6): a025486. doi:10.1101/cshperspect.a025486. PMC 5453383. PMID 28242785.
- ↑ Sturm, A. (2006). "Manipulation of Host Hepatocytes by the Malaria Parasite for Delivery into Liver Sinusoids". Science. 313 (5791): 1287–1290. Bibcode:2006Sci...313.1287S. doi:10.1126/science.1129720. PMID 16888102. S2CID 22790721.
- ↑ 23.0 23.1 Cowman, Alan F.; Crabb, Brendan S. (2006). "Invasion of Red Blood Cells by Malaria Parasites". Cell. 124 (4): 755–766. doi:10.1016/j.cell.2006.02.006. PMID 16497586. S2CID 14972823.
- ↑ "Malaria eModule – SYNCHRONICITY". Archived from the original on 2007-12-22. Retrieved 2023-05-19.
- ↑ Jensen, Anja Ramstedt; Adams, Yvonne; Hviid, Lars (2020). "Cerebral Plasmodium falciparum malaria: The role of PfEMP1 in its pathogenesis and immunity, and PfEMP1-based vaccines to prevent it". Immunological Reviews. 293 (1): 230–252. doi:10.1111/imr.12807. PMC 6972667. PMID 31562653.
- ↑ Pagola S, Stephens PW, Bohle DS, Kosar AD, Madsen SK (2000). "The structure of malaria pigment beta-haematin". Nature. 404 (6775): 307–310. Bibcode:2000Natur.404..307P. doi:10.1038/35005132. PMID 10749217. S2CID 4420567.
- ↑ Hempelmann E (2007). "Hemozoin biocrystallization in Plasmodium falciparum and the antimalarial activity of crystallization inhibitors". Parasitol Research. 100 (4): 671–676. doi:10.1007/s00436-006-0313-x. PMID 17111179. S2CID 30446678. Archived from the original on 2011-06-10.
- ↑ 28.0 28.1 "Malaria eModule – ASEXUAL ERYTHROCYTIC STAGES". Archived from the original on 2007-12-22. Retrieved 2023-05-19.
- ↑ Read, M.; Sherwin, T.; Holloway, S. P.; Gull, K.; Hyde, J. E. (1993). "Microtubular organization visualized by immunofluorescence microscopy during erythrocytic schizogony in Plasmodium falciparum and investigation of post-translational modifications of parasite tubulin". Parasitology. 106 (3): 223–232. doi:10.1017/s0031182000075041. PMID 8488059. S2CID 24655319.
- ↑ Arnot, D. E.; Ronander, E.; Bengtsson, D. C. (2011). "The progression of the intra-erythrocytic cell cycle of Plasmodium falciparum and the role of the centriolar plaques in asynchronous mitotic division during schizogony". Int. J. Parasitol. 41 (1): 71–80. doi:10.1016/j.ijpara.2010.07.012. PMID 20816844.
- ↑ 31.0 31.1 31.2 31.3 31.4 Trampuz, Andrej; Jereb, Matjaz; Muzlovic, Igor; Prabhu, Rajesh M (2003). "Clinical review: Severe malaria". Critical Care. 7 (4): 315–23. doi:10.1186/cc2183. PMC 270697. PMID 12930555.
- ↑ Talman, Arthur M; Domarle, Olivier; McKenzie, F; Ariey, Frédéric; Robert, Vincent (2004). "Gametocytogenesis: the puberty of Plasmodium falciparum". Malaria Journal. 3 (1): 24. doi:10.1186/1475-2875-3-24. PMC 497046. PMID 15253774.
- ↑ Bartoloni, A; Zammarchi, L (2012). "Clinical aspects of uncomplicated and severe malaria". Mediterranean Journal of Hematology and Infectious Diseases. 4 (1): e2012026. doi:10.4084/MJHID.2012.026. PMC 3375727. PMID 22708041.
- ↑ D'Ortenzio, E; Godineau, N; Fontanet, A; Houze, S; Bouchaud, O; Matheron, S; Le Bras, J (2008). "Prolonged Plasmodium falciparum infection in immigrants, Paris". Emerging Infectious Diseases. 14 (2): 323–326. doi:10.3201/eid1402.061475. PMC 2600192. PMID 18258132.
- ↑ Sinden, R. E.; Canning, E. U.; Bray, R. S.; Smalley, M. E. (1978). "Gametocyte and Gamete Development in Plasmodium falciparum". Proceedings of the Royal Society B: Biological Sciences. 201 (1145): 375–399. Bibcode:1978RSPSB.201..375S. doi:10.1098/rspb.1978.0051. PMID 27809. S2CID 27083717.
- ↑ Rungsiwongse, Jarasporn; Rosenberg, Ronald (1991). "The Number of Sporozoites Produced by Individual Malaria Oocysts". The American Journal of Tropical Medicine and Hygiene. 45 (5): 574–577. doi:10.4269/ajtmh.1991.45.574. PMID 1951866.
- ↑ Beier, JC; Onyango, FK; Koros, JK; Ramadhan, M; Ogwang, R; Wirtz, RA; Koech, DK; Roberts, CR (1991). "Quantitation of malaria sporozoites transmitted in vitro during salivation by wild Afrotropical Anopheles". Medical and Veterinary Entomology. 5 (1): 71–9. doi:10.1111/j.1365-2915.1991.tb00523.x. PMID 1768903. S2CID 27449694.
- ↑ 38.0 38.1 Chakravarty, Sumana; Cockburn, Ian A; Kuk, Salih; Overstreet, Michael G; Sacci, John B; Zavala, Fidel (2007). "CD8+ T lymphocytes protective against malaria liver stages are primed in skin-draining lymph nodes". Nature Medicine. 13 (9): 1035–1041. doi:10.1038/nm1628. PMID 17704784. S2CID 17601147.
- ↑ Hopp, Christine S.; Sinnis, Photini (2015). "The innate and adaptive response to mosquito saliva and Plasmodium sporozoites in the skin". Annals of the New York Academy of Sciences. 1342 (1): 37–43. Bibcode:2015NYASA1342...37H. doi:10.1111/nyas.12661. PMC 4405444. PMID 25694058.
- ↑ Gomes, Pollyanna S.; Bhardwaj, Jyoti; Rivera-Correa, Juan; Freire-De-Lima, Celio G.; Morrot, Alexandre (2016). "Immune Escape Strategies of Malaria Parasites". Frontiers in Microbiology. 7: e1617. doi:10.3389/fmicb.2016.01617. PMC 5066453. PMID 27799922.
- ↑ Artavanis-Tsakonas, K; Tongren, JE; Riley, EM (August 2003). "The war between the malaria parasite and the immune system: immunity, immunoregulation and immunopathology". Clinical and Experimental Immunology. 133 (2): 145–152. doi:10.1046/j.1365-2249.2003.02174.x. PMC 1808775. PMID 12869017.

- ↑ 42.0 42.1 Florens, Laurence; Washburn, Michael P.; Raine, J. Dale; Anthony, Robert M.; Grainger, Munira; Haynes, J. David; Moch, J. Kathleen; Muster, Nemone; et al. (3 October 2002). "A proteomic view of the Plasmodium falciparum life cycle". Nature. 419 (6906): 520–526. Bibcode:2002Natur.419..520F. doi:10.1038/nature01107. PMID 12368866. S2CID 4412848.
- ↑ Cerami, Carla; Frevert, Ute; Sinnis, Photini; Takacs, Bela; Clavijo, Pedro; Santos, Manuel J.; Nussenzweig, Victor (1992). "The basolateral domain of the hepatocyte plasma membrane bears receptors for the circumsporozoite protein of Plasmodium falciparum sporozoites". Cell. 70 (6): 1021–1033. doi:10.1016/0092-8674(92)90251-7. PMID 1326407. S2CID 8825913.
- ↑ Baldacci, Patricia; Ménard, Robert (2004). "The elusive malaria sporozoite in the mammalian host". Molecular Microbiology. 54 (2): 298–306. doi:10.1111/j.1365-2958.2004.04275.x. PMID 15469504. S2CID 30488807.
- ↑ Vaughan, Ashley M.; Aly, Ahmed S.I.; Kappe, Stefan H.I. (2008). "Malaria Parasite Pre-Erythrocytic Stage Infection: Gliding and Hiding". Cell Host & Microbe. 4 (3): 209–218. doi:10.1016/j.chom.2008.08.010. PMC 2610487. PMID 18779047.
- ↑ Satchwell, T. J. (2016). "Erythrocyte invasion receptors for Plasmodium falciparum: new and old". Transfusion Medicine. 26 (2): 77–88. doi:10.1111/tme.12280. hdl:1983/2945cc98-49e8-4c37-a392-88e35fab588c. PMID 26862042. S2CID 7811400. Archived from the original on 2023-07-01. Retrieved 2023-05-19.
- ↑ Lalchhandama, Kholhring (2017). "Plasmodium falciparum erythrocyte membrane protein 1". WikiJournal of Medicine. 4 (1): 1–8. doi:10.15347/wjm/2017.004.
- ↑ Tatem AJ, Jia P, Ordanovich D, Falkner M, Huang Z, Howes R; et al. (2017). "The geography of imported malaria to non-endemic countries: a meta-analysis of nationally reported statistics". Lancet Infect Dis. 17 (1): 98–107. doi:10.1016/S1473-3099(16)30326-7. PMC 5392593. PMID 27777030.
{{cite journal}}: CS1 maint: multiple names: authors list (link) - ↑ Majori, Giancarlo (2012). "Short History of Malaria and Its Eradication in Italy With Short Notes on the Fight Against the Infection in the Mediterranean Basin". Mediterranean Journal of Hematology and Infectious Diseases. 4 (1): e2012016. doi:10.4084/MJHID.2012.016. ISSN 2035-3006. PMC 3340992. PMID 22550561.
- ↑ Kitron, U.; Spielman, A. (1989). "Suppression of transmission of malaria through source reduction: antianopheline measures applied in Israel, the United States, and Italy". Reviews of Infectious Diseases. 11 (3): 391–406. doi:10.1093/clinids/11.3.391. ISSN 0162-0886. PMID 2665000. Archived from the original on 2023-04-06. Retrieved 2023-05-19.
- ↑ Martini, Mariano; Angheben, Andrea; Riccardi, Niccolò; Orsini, Davide (2021). "Fifty years after the eradication of Malaria in Italy. The long pathway toward this great goal and the current health risks of imported malaria". Pathogens and Global Health. 115 (4): 215–223. doi:10.1080/20477724.2021.1894394. ISSN 2047-7732. PMC 8168761. PMID 33734023.
- ↑ Piperaki, E.T.; Daikos, G.L. (2016). "Malaria in Europe: emerging threat or minor nuisance?". Clinical Microbiology and Infection. 22 (6): 487–493. doi:10.1016/j.cmi.2016.04.023. PMID 27172807.
- ↑ Bousema, T.; Drakeley, C. (2011). "Epidemiology and Infectivity of Plasmodium falciparum and Plasmodium vivax Gametocytes in Relation to Malaria Control and Elimination". Clinical Microbiology Reviews. 24 (2): 377–410. doi:10.1128/CMR.00051-10. PMC 3122489. PMID 21482730.
- ↑ 54.0 54.1 Crutcher, James M.; Hoffman, Stephen L. (1996), Baron, Samuel (ed.), "Malaria", Medical Microbiology (4th ed.), Galveston (TX): University of Texas Medical Branch at Galveston, ISBN 978-0-9631172-1-2, PMID 21413352, archived from the original on 2021-04-23, retrieved 2022-02-01
- ↑ Buchanan, Andrew (1901). "Malignant Tertian Fever". The Indian Medical Gazette. 36 (7): 256–258. ISSN 0019-5863. PMC 5164271. PMID 29004267.
- ↑ Hemmer, C. J.; Loebermann, M.; Reisinger, E. C. (2016). "Fever after travel to tropical regions: Malaria and other emergencies". Notfall & Rettungsmedizin. 19 (4): 263–268. doi:10.1007/s10049-016-0176-3. ISSN 1434-6222. PMC 7101662. PMID 32288635.
- ↑ Corbett, Yolanda; Parapini, Silvia; Perego, Federica; Messina, Valeria; Delbue, Serena; Misiano, Paola; Falchi, Mario; Silvestrini, Francesco; Taramelli, Donatella; Basilico, Nicoletta; D'Alessandro, Sarah (2021). "Phagocytosis and activation of bone marrow-derived macrophages by Plasmodium falciparum gametocytes". Malaria Journal. 20 (1): 81. doi:10.1186/s12936-021-03589-2. ISSN 1475-2875. PMC 7874634. PMID 33568138.
- ↑ Coronado, Lorena M.; Nadovich, Christopher T.; Spadafora, Carmenza (2014). "Malarial Hemozoin: From target to tool". Biochimica et Biophysica Acta (BBA) - General Subjects. 1840 (6): 2032–2041. doi:10.1016/j.bbagen.2014.02.009. ISSN 0006-3002. PMC 4049529. PMID 24556123.
- ↑ Tyberghein, Ariane; Deroost, Katrien; Schwarzer, Evelin; Arese, Paolo; Van den Steen, Philippe E. (2014). "Immunopathological effects of malaria pigment or hemozoin and other crystals". BioFactors. 40 (1): 59–78. doi:10.1002/biof.1119. ISSN 1872-8081. PMID 23907956. S2CID 45386035. Archived from the original on 2023-04-08. Retrieved 2023-05-19.
- ↑ Deroost, Katrien; Lays, Natacha; Noppen, Sam; Martens, Erik; Opdenakker, Ghislain; Van den Steen, Philippe E. (2012). "Improved methods for haemozoin quantification in tissues yield organ-and parasite-specific information in malaria-infected mice". Malaria Journal. 11: 166. doi:10.1186/1475-2875-11-166. ISSN 1475-2875. PMC 3473299. PMID 22583751.
- ↑ Pek, Rini H.; Yuan, Xiaojing; Rietzschel, Nicole; Zhang, Jianbing; Jackson, Laurie; Nishibori, Eiji; Ribeiro, Ana; Simmons, William; Jagadeesh, Jaya; Sugimoto, Hiroshi; Alam, Md Zahidul (2019). "Hemozoin produced by mammals confers heme tolerance". eLife. 8: e49503. doi:10.7554/eLife.49503. ISSN 2050-084X. PMC 6773446. PMID 31571584.
- ↑ Olivier, Martin; Van Den Ham, Kristin; Shio, Marina Tiemi; Kassa, Fikregabrail Aberra; Fougeray, Sophie (2014). "Malarial pigment hemozoin and the innate inflammatory response". Frontiers in Immunology. 5: 25. doi:10.3389/fimmu.2014.00025. ISSN 1664-3224. PMC 3913902. PMID 24550911.
- ↑ Shio, Marina T.; Kassa, Fikregabrail A.; Bellemare, Marie-Josée; Olivier, Martin (2010). "Innate inflammatory response to the malarial pigment hemozoin". Microbes and Infection. 12 (12–13): 889–899. doi:10.1016/j.micinf.2010.07.001. ISSN 1769-714X. PMID 20637890. Archived from the original on 2023-04-07. Retrieved 2023-05-19.
- ↑ 64.0 64.1 Moya-Alvarez, Violeta; Abellana, Rosa; Cot, Michel (2014). "Pregnancy-associated malaria and malaria in infants: an old problem with present consequences". Malaria Journal. 13 (1): 271. doi:10.1186/1475-2875-13-271. PMC 4113781. PMID 25015559.
- ↑ Kourtis, Athena P.; Read, Jennifer S.; Jamieson, Denise J. (2014). "Pregnancy and Infection". New England Journal of Medicine. 370 (23): 2211–2218. doi:10.1056/NEJMra1213566. PMC 4459512. PMID 24897084.
- ↑ Tembo, Dumizulu L.; Nyoni, Benjamin; Murikoli, Rekah V.; Mukaka, Mavuto; Milner, Danny A.; Berriman, Matthew; Rogerson, Stephen J.; Taylor, Terrie E.; Molyneux, Malcolm E.; Mandala, Wilson L.; Craig, Alister G. (2014). "Differential PfEMP1 expression is associated with cerebral malaria pathology". PLOS Pathogens. 10 (12): e1004537. doi:10.1371/journal.ppat.1004537. PMC 4256257. PMID 25473835.
- ↑ Dondorp AM, Pongponratn E, White NJ (February 2004). "Reduced microcirculatory flow in severe falciparum malaria: pathophysiology and electron-microscopic pathology". Acta Trop. 89 (3): 309–17. doi:10.1016/j.actatropica.2003.10.004. PMID 14744557.
- ↑ Anonymous (2000). "Severe falciparum malaria. World Health Organization, Communicable Diseases Cluster". Transactions of the Royal Society of Tropical Medicine and Hygiene. 94 Suppl 1: S1–90. ISSN 0035-9203. PMID 11103309. Archived from the original on 2023-04-06. Retrieved 2023-05-19.
- ↑ Omar, Mohamed; Marchionni, Luigi; Häcker, Georg; Badr, Mohamed Tarek (2021). "Host Blood Gene Signatures Can Detect the Progression to Severe and Cerebral Malaria". Frontiers in Cellular and Infection Microbiology. 11: 743616. doi:10.3389/fcimb.2021.743616. ISSN 2235-2988. PMC 8569259. PMID 34746025.
- ↑ Murphy, S. C.; Breman, J. G. (2001). "Gaps in the childhood malaria burden in Africa: cerebral malaria, neurological sequelae, anemia, respiratory distress, hypoglycemia, and complications of pregnancy". The American Journal of Tropical Medicine and Hygiene. 64 (1-2 Suppl): 57–67. doi:10.4269/ajtmh.2001.64.57. PMID 11425178. S2CID 847217. Archived from the original on 2021-12-07. Retrieved 2023-05-19.
- ↑ Breman, J. G. (2001). "The ears of the hippopotamus: manifestations, determinants, and estimates of the malaria burden". The American Journal of Tropical Medicine and Hygiene. 64 (1-2 Suppl): 1–11. doi:10.4269/ajtmh.2001.64.1. ISSN 0002-9637. PMID 11425172. Archived from the original on 2022-11-16. Retrieved 2023-05-19.
- ↑ Luzolo, Ange Landela; Ngoyi, Dieudonné Mumba (2019). "Cerebral malaria". Brain Research Bulletin. 145: 53–58. doi:10.1016/j.brainresbull.2019.01.010. ISSN 1873-2747. PMID 30658131. S2CID 58560596. Archived from the original on 2023-04-26. Retrieved 2023-05-19.
- ↑ Idro, Richard; Marsh, Kevin; John, Chandy C; Newton, Charles RJ (2010). "Cerebral Malaria; Mechanisms Of Brain Injury And Strategies For Improved Neuro-Cognitive Outcome". Pediatric Research. 68 (4): 267–274. doi:10.1203/PDR.0b013e3181eee738. ISSN 0031-3998. PMC 3056312. PMID 20606600.
- ↑ Shanks, G. Dennis (2015). "Historical review: does stress provoke Plasmodium falciparum recrudescence?". Transactions of the Royal Society of Tropical Medicine and Hygiene. 109 (6): 360–365. doi:10.1093/trstmh/trv032. ISSN 1878-3503. PMID 25918217. Archived from the original on 2023-04-07. Retrieved 2023-05-19.
- ↑ Teuscher, Franka; Gatton, Michelle L.; Chen, Nanhua; Peters, Jennifer; Kyle, Dennis E.; Cheng, Qin (2010). "Artemisinin‐induced dormancy in plasmodium falciparum: duration, recovery rates, and implications in treatment failure". The Journal of Infectious Diseases. 202 (9): 1362–1368. doi:10.1086/656476. ISSN 1537-6613. PMC 2949454. PMID 20863228.
- ↑ WorldWide Antimalarial Resistance Network (WWARN) Lumefantrine PK/PD Study Group (2015). "Artemether-lumefantrine treatment of uncomplicated Plasmodium falciparum malaria: a systematic review and meta-analysis of day 7 lumefantrine concentrations and therapeutic response using individual patient data". BMC Medicine. 13: 227. doi:10.1186/s12916-015-0456-7. ISSN 1741-7015. PMC 4574542. PMID 26381375.
- ↑ Al Hammadi, Ahmed; Mitchell, Michael; Abraham, George M.; Wang, Jennifer P. (2017). "Recrudescence of Plasmodium falciparum in a Primigravida After Nearly 3 Years of Latency". The American Journal of Tropical Medicine and Hygiene. 96 (3): 642–644. doi:10.4269/ajtmh.16-0803. ISSN 1476-1645. PMC 5361538. PMID 28044045.
- ↑ Salas-Coronas, Joaquín; Soriano-Pérez, Manuel Jesús; Lozano-Serrano, Ana B.; Pérez-Moyano, Rosario; Porrino-Herrera, Carmen; Cabezas-Fernández, María Teresa (2017). "Symptomatic Falciparum Malaria After Living in a Nonendemic Area for 10 Years: Recrudescence or Indigenous Transmission?". The American Journal of Tropical Medicine and Hygiene. 96 (6): 1427–1429. doi:10.4269/ajtmh.17-0031. ISSN 1476-1645. PMC 5462582. PMID 28719260.
- ↑ Ismail, Arif; Auclair, Francois; McCarthy, Anne E. (2020). "Recrudescence of chronic Plasmodium falciparum malaria 13 years after exposure". Travel Medicine and Infectious Disease. 33: 101518. doi:10.1016/j.tmaid.2019.101518. ISSN 1873-0442. PMID 31712180. S2CID 207949553. Archived from the original on 2023-04-06. Retrieved 2023-05-19.
- ↑ Mayor, Alfredo; Serra-Casas, Elisa; Bardají, Azucena; Sanz, Sergi; Puyol, Laura; Cisteró, Pau; Sigauque, Betuel; Mandomando, Inacio; Aponte, John J.; Alonso, Pedro L.; Menéndez, Clara (2009). "Sub-microscopic infections and long-term recrudescence of Plasmodium falciparum in Mozambican pregnant women". Malaria Journal. 8: 9. doi:10.1186/1475-2875-8-9. ISSN 1475-2875. PMC 2633011. PMID 19134201.
- ↑ Laochan, Natthapon; Zaloumis, Sophie G.; Imwong, Mallika; Lek-Uthai, Usa; Brockman, Alan; Sriprawat, Kanlaya; Wiladphaingern, Jacher; White, Nicholas J.; Nosten, François; McGready, Rose (2015). "Intervals to Plasmodium falciparum recurrence after anti-malarial treatment in pregnancy: a longitudinal prospective cohort". Malaria Journal. 14: 221. doi:10.1186/s12936-015-0745-9. ISSN 1475-2875. PMC 4449611. PMID 26017553.
- ↑ Kwiatkowski DP (2005). "How malaria has affected the human genome and what human genetics can teach us about malaria". American Journal of Human Genetics. 77 (2): 171–92. doi:10.1086/432519. PMC 1224522. PMID 16001361.

- ↑ Hedrick PW (2011). "Population genetics of malaria resistance in humans". Heredity. 107 (4): 283–304. doi:10.1038/hdy.2011.16. PMC 3182497. PMID 21427751.

- ↑ Beet, EA (1946). "Sickle cell disease in the Balovale District of Northern Rhodesia". East African Medical Journal. 23: 75–86. PMID 21027890.
- ↑ Hedrick, P W (2011). "Population genetics of malaria resistance in humans". Heredity. 107 (4): 283–304. doi:10.1038/hdy.2011.16. PMC 3182497. PMID 21427751.
- ↑ Chotivanich, K; Udomsangpetch, R; Pattanapanyasat, K; Chierakul, W; Simpson, J; Looareesuwan, S; White, N (2002). "Hemoglobin E: a balanced polymorphism protective against high parasitemias and thus severe P falciparum malaria". Blood. 100 (4): 1172–6. doi:10.1182/blood.V100.4.1172.h81602001172_1172_1176. PMID 12149194.
- ↑ Verra, Federica; Simpore, Jacques; Warimwe, George M.; Tetteh, Kevin K.; Howard, Tevis; Osier, Faith H. A.; Bancone, Germana; Avellino, Pamela; et al. (3 October 2007). "Haemoglobin C and S Role in Acquired Immunity against Plasmodium falciparum Malaria". PLOS ONE. 2 (10): e978. Bibcode:2007PLoSO...2..978V. doi:10.1371/journal.pone.0000978. PMC 1991593. PMID 17912355.
- ↑ Matuschewski, Kai (2017). "Vaccines against malaria-still a long way to go". The FEBS Journal. 284 (16): S0264–410X(16)30982–3. doi:10.1111/febs.14107. PMID 28500775.
- ↑ Mahmoudi, Shima; Keshavarz, Hossein (2017). "Efficacy of phase 3 trial of RTS, S/AS01 malaria vaccine: The need for an alternative development plan". Human Vaccines & Immunotherapeutics. 13 (9): 2098–2101. doi:10.1080/21645515.2017.1295906. PMC 5612527. PMID 28272979.
- ↑ "WHO recommends groundbreaking malaria vaccine for children at risk". www.who.int. Archived from the original on 2021-10-07. Retrieved 2021-11-15.
- ↑ 91.0 91.1 91.2 91.3 91.4 91.5 91.6 91.7 91.8 Guidelines for the treatment of malaria, second edition Authors: WHO. Number of pages: 194. Publication date: 2010. Languages: English. ISBN 978-92-4-154792-5
- ↑ Greenwood, David (1992). "The quinine connection". Journal of Antimicrobial Chemotherapy. 30 (4): 417–427. doi:10.1093/jac/30.4.417. PMID 1490916.
- ↑ Kaufman, Teodoro S.; Rúveda, Edmundo A. (28 January 2005). "The Quest for Quinine: Those Who Won the Battles and Those Who Won the War". Angewandte Chemie International Edition. 44 (6): 854–885. doi:10.1002/anie.200400663. PMID 15669029.
- ↑ Todd, L.; Cornforth, J.; T., A. R.; C., J. W. (1981). "Robert Burns Woodward. 10 April 1917-8 July 1979". Biographical Memoirs of Fellows of the Royal Society. 27: 628–695. doi:10.1098/rsbm.1981.0025.
- ↑ Bispham, W. N. (1941). "Toxic Reactions Following the Use of Atabrine in Malaria 1". The American Journal of Tropical Medicine and Hygiene. s1-21 (3): 455–459. doi:10.4269/ajtmh.1941.s1-21.455.
- ↑ Su, Xin-Zhuan; Miller, Louis H. (2015). "The discovery of artemisinin and the Nobel Prize in Physiology or Medicine". Science China Life Sciences. 58 (11): 1175–1179. doi:10.1007/s11427-015-4948-7. PMC 4966551. PMID 26481135.
- ↑ De Flora, S; La Maestra, S (2015). "Epidemiology of cancers of infectious origin and prevention strategies". Journal of Preventive Medicine and Hygiene. 56 (1): E15–20. doi:10.15167/2421-4248/jpmh2015.56.1.470. PMC 4718340. PMID 26789827.

- ↑ Bouvard, Véronique; Baan, Robert; Straif, Kurt; Grosse, Yann; Secretan, Béatrice; Ghissassi, Fatiha El; Benbrahim-Tallaa, Lamia; Guha, Neela; et al. (2009). "A review of human carcinogens—Part B: biological agents" (PDF). The Lancet Oncology. 10 (4): 321–322. doi:10.1016/S1470-2045(09)70096-8. PMID 19350698. Archived (PDF) from the original on 2023-05-22. Retrieved 2023-05-19.
- ↑ Geser, A.; Brubaker, G.; Draper, C.C. (1989). "Effect of a malaria suppression program on the incidence of African Burkitt's lymphoma". American Journal of Epidemiology. 129 (4): 740–752. doi:10.1093/oxfordjournals.aje.a115189. PMID 2923122.
- ↑ Rajcani, Julius; Szenthe, Kalman; Banati, Ferenc; Szathmary, Susan (2014). "Survey of Epstein Barr Virus (EBV) Immunogenic Proteins and their Epitopes: Implications for Vaccine Preparation". Recent Patents on Anti-Infective Drug Discovery. 9 (1): 62–76. doi:10.2174/1574891X09666140828114812. PMID 25164057.
- ↑ Wang, Yuyan; Banerjee, Shuvomoy; Ding, Ling; Cai, Cankun; Wei, Fang; Cai, Qiliang (2017). "The regulatory role of protein phosphorylation in human gammaherpesvirus associated cancers". Virologica Sinica. 32 (5): 357–368. doi:10.1007/s12250-017-4081-9. PMC 6704201. PMID 29116588.
- ↑ van Tong, Hoang; Brindley, Paul J.; Meyer, Christian G.; Velavan, Thirumalaisamy P. (2017). "Parasite Infection, Carcinogenesis and Human Malignancy". EBioMedicine. 15: 12–23. doi:10.1016/j.ebiom.2016.11.034. PMC 5233816. PMID 27956028.

- ↑ Thorley-Lawson, David; Deitsch, Kirk W.; Duca, Karen A.; Torgbor, Charles; Knoll, Laura J (2016). "The Link between Plasmodium falciparum Malaria and Endemic Burkitt's Lymphoma—New Insight into a 50-Year-Old Enigma". PLOS Pathogens. 12 (1): e1005331. doi:10.1371/journal.ppat.1005331. PMC 4721646. PMID 26794909.

- ↑ Baron, Christopher; Hamlin, Christopher (2015). "Malaria and the Decline of Ancient Greece: Revisiting the Jones Hypothesis in an Era of Interdisciplinarity". Minerva. 53 (4): 327–358. doi:10.1007/s11024-015-9280-7. S2CID 142602810.
- ↑ 105.0 105.1 Hempelmann, Ernst; Krafts, Kristine (2013). "Bad air, amulets and mosquitoes: 2,000?years of changing perspectives on malaria". Malaria Journal. 12 (1): 232. doi:10.1186/1475-2875-12-232. PMC 3723432. PMID 23835014.
- ↑ Nerlich, A (2016). "Paleopathology and Paleomicrobiology of Malaria". Paleomicrobiology of Humans. Microbiology Spectrum. Vol. 4. pp. 155–160. doi:10.1128/microbiolspec.PoH-0006-2015. ISBN 9781555819163. PMID 27837743.
- ↑ 107.0 107.1 107.2 Lalchhandama, K. (2014). "The making of modern malariology: from miasma to mosquito- malaria theory" (PDF). Science Vision. 14 (1): 3–17. Archived from the original (PDF) on 2014-04-27.
- ↑ Cox, Francis EG (2010). "History of the discovery of the malaria parasites and their vectors". Parasites & Vectors. 3 (1): 5. doi:10.1186/1756-3305-3-5. PMC 2825508. PMID 20205846.

- ↑ Baccetti, B (2008). "History of the early dipteran systematics in Italy: from Lyncei to Battista Grassi". Parassitologia. 50 (3–4): 167–172. PMID 20055226.
- ↑ Capanna, E (2006). "Grassi versus Ross: who solved the riddle of malaria?". International Microbiology. 9 (1): 69–74. PMID 16636993.
- ↑ 111.0 111.1 Bruce-Chwatt, L.J. (1987). "Falciparum nomenclature". Parasitology Today. 3 (8): 252. doi:10.1016/0169-4758(87)90153-0. PMID 15462972.
- ↑ Christophers, R; Sinton, JA (1938). "Correct Name of Malignant Tertian Parasite". British Medical Journal. 2 (4065): 1130–1134. doi:10.1136/bmj.2.4065.1130. PMC 2211005. PMID 20781927.
- ↑ Liu, W; Li, Y; Learn, GH; Rudicell, RS; Robertson, JD; Keele, BF; Ndjango, JB; Sanz, CM; et al. (2010). "Origin of the human malaria parasite Plasmodium falciparum in gorillas". Nature. 467 (7314): 420–5. Bibcode:2010Natur.467..420L. doi:10.1038/nature09442. PMC 2997044. PMID 20864995.
- ↑ Holmes, Edward C. (2010). "Malaria: The gorilla connection". Nature. 467 (7314): 404–405. Bibcode:2010Natur.467..404H. doi:10.1038/467404a. PMID 20864986. S2CID 205058952.
- ↑ 115.0 115.1 115.2 Liu, W; Y Li, GH Learn, RS Rudicell, JD Robertson, BF Keele, JN Ndjango, CM Sanz, DB Morgan, S Locatelli, MK Gonder, PJ Kranzusch, PD Walsh, E Delaporte, E Mpoudi-Ngole, AV Georgiev, MN Muller, GM Shaw, M Peeters, PM Sharp, JC Rayner, BH Hahn (2010). "Origin of the human malaria parasite Plasmodium falciparum in gorillas". Nature. 467 (7314): 420–5. Bibcode:2010Natur.467..420L. doi:10.1038/nature09442. PMC 2997044. PMID 20864995.
{{cite journal}}: CS1 maint: multiple names: authors list (link) - ↑ Duval, L; M Fourment, E Nerrienet, D Rousset, SA Sadeuh, SM Goodman, NV Andriaholinirina, M Randrianarivelojosia, RE Paul, V Robert, FJ Ayala, F Ariey (2010). "African apes as reservoirs of Plasmodium falciparum and the origin and diversification of the Laverania subgenus". Proceedings of the National Academy of Sciences of the United States of America. 107 (23): 10561–6. Bibcode:2010PNAS..10710561D. doi:10.1073/pnas.1005435107. PMC 2890828. PMID 20498054.
{{cite journal}}: CS1 maint: multiple names: authors list (link) - ↑ Rayner, J; WM Liu, M Peeters, PM Sharp, BH Hahn (2011). "A plethora of Plasmodium species in wild apes: a source of human infection?". Trends in Parasitology. 27 (5): 222–229. doi:10.1016/J.Pt.2011.01.006. PMC 3087880. PMID 21354860.
{{cite journal}}: CS1 maint: multiple names: authors list (link) - ↑ Rathore, D; Wahl AM, Sullivan M, McCutchan TF (2001-04-25). "A phylogenetic comparison of gene trees constructed from plastid, mitochondrial and genomic DNA of Plasmodium species". Molecular and Biochemical Parasitology. 114 (1): 89–94. doi:10.1016/S0166-6851(01)00241-9. PMID 11356517. Archived from the original on 2023-04-06. Retrieved 2023-05-19.
{{cite journal}}: CS1 maint: multiple names: authors list (link) - ↑ Hartl, DH (January 2004). "The origin of malaria: mixed messages from genetic diversity". Nature Reviews Microbiology. 2 (1): 15–22. doi:10.1038/nrmicro795. PMID 15035005. S2CID 11020105.
- ↑ Hume, J.C.; Lyons, E.J.; Day, K.P. (2003). "Human migration, mosquitoes and the evolution of Plasmodium falciparum". Trends Parasitol. 19 (3): 144–9. doi:10.1016/s1471-4922(03)00008-4. PMID 12643998.
Further reading[edit | edit source]
- Colombian scientists develop computational tool to detect Plasmodium falciparum (in Spanish)
- Allison, A.C. (February 1954). "Protection Afforded by Sickle-cell Trait Against Subtertian Malarial Infection". Br Med J. 1 (4857): 290–4. doi:10.1136/bmj.1.4857.290. PMC 2093356. PMID 13115700.
- Allison, AC (1964). "Polymorphism and Natural Selection in Human Populations". Cold Spring Harb. Symp. Quant. Biol. 29: 137–49. doi:10.1101/sqb.1964.029.01.018. PMID 14278460.
- Cholera, R; Brittain NJ; Gillrie MR; et al. (January 2008). "Impaired cytoadherence of Plasmodium falciparum-infected erythrocytes containing sickle hemoglobin". Proc. Natl. Acad. Sci. U.S.A. 105 (3): 991–6. Bibcode:2008PNAS..105..991C. doi:10.1073/pnas.0711401105. PMC 2242681. PMID 18192399.
- Mockenhaupt, FP; Ehrhardt, S; Otchwemah, R; et al. (May 2004). "Limited influence of haemoglobin variants on Plasmodium falciparum msp1 and msp2 alleles in symptomatic malaria". Trans. R. Soc. Trop. Med. Hyg. 98 (5): 302–10. doi:10.1016/j.trstmh.2003.10.001. PMID 15109555.
- Roberts, Larry S.; Janovy, John (2005). Foundations of Parasitology (7th ed.). McGraw-Hill Education (ISE Editions). ISBN 978-0-07-111271-0.
External links[edit | edit source]
- Malaria species info at CDC Archived 2023-07-01 at the Wayback Machine
- Web Atlas of Medical Parasitology Archived 2023-04-06 at the Wayback Machine
- Species profile at Encyclopedia of Life Archived 2018-01-13 at the Wayback Machine
- Taxonomy at UniProt Archived 2023-04-06 at the Wayback Machine
- Profile at Scientists Against Malaria Archived 2023-04-08 at the Wayback Machine
- Clinical Identification Case 1
- Clinical Identification Case 2
- Genome info at Wellcome Trust Sanger Institute Archived 2023-03-21 at the Wayback Machine
- PlasmoDB: The Plasmodium Genome Resource Archived 2003-09-20 at the Wayback Machine
- GeneDB Plasmodium falciparum gene info
- Genome
- UCSC Plasmodium Falciparum Browser Archived 2007-11-11 at the Wayback Machine
- Gene info at Kyoto University Archived 2023-04-06 at the Wayback Machine
Categories: [Plasmodium] [Pathogenic microbes] [Parasites of humans] [Articles containing video clips] [Malaria] [Species described in 1881] [Protozoal diseases] [IARC Group 2A carcinogens] [Infectious causes of cancer]
↧ Download as ZWI file | Last modified: 05/03/2024 23:01:28 | 2 views
☰ Source: https://mdwiki.org/wiki/Plasmodium_falciparum | License: CC BY-SA 3.0

KSF
KSF